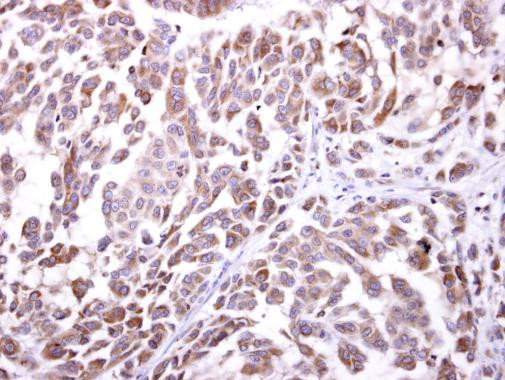
NKG2D Antibody in Immunohistochemistry (Paraffin) (IHC (P))

Search
Invitrogen
NKG2D Polyclonal Antibody
{{$productOrderCtrl.translations['antibody.pdp.commerceCard.promotion.promotions']}}
{{$productOrderCtrl.translations['antibody.pdp.commerceCard.promotion.viewpromo']}}
{{$productOrderCtrl.translations['antibody.pdp.commerceCard.promotion.promocode']}}: {{promo.promoCode}} {{promo.promoTitle}} {{promo.promoDescription}}. {{$productOrderCtrl.translations['antibody.pdp.commerceCard.promotion.learnmore']}}
产品信息
PA5-85205
种属反应
宿主/亚型
分类
类型
抗原
偶联物
形式
浓度
规格
纯化类型
保存液
内含物
保存条件
运输条件
RRID
产品详细信息
Keep as concentrated solution.
Predicted reactivity: Chimpanzee (100%).
Positive Control: human spleen.
Store product as a concentrated solution. Centrifuge briefly prior to opening the vial.
靶标信息
Natural killer (NK) cells are lymphocytes that can mediate lysis of certain tumor cells and virus-infected cells without previous activation. NK cells can regulate specific humoral and cell-mediated immunity, and preferentially express several calcium-dependent (C-type) lectins, which have been implicated in the regulation of NK cell function. The NK gene encodes a member of the NKG2 family, and the encoded transmembrane protein is characterized by a type II membrane orientation (extracellular C terminus) and the presence of a C-type lectin domain. The NKG2 gene family is located within the NK complex, a region that contains several C-type lectin genes preferentially expressed in NK cells.
仅用于科研。不用于诊断过程。未经明确授权不得转售。
篇参考文献 (0)
生物信息学
蛋白别名: CD314; Killer cell lectin-like receptor subfamily K member 1; killer cell lectin-like receptor subfamily K, member 1; natural killer cell receptor; NK cell receptor D; NKG2-D type II integral membrane protein; NKG2-D-activating NK receptor; unnamed protein product
基因别名: CD314; D12S2489E; KLR; KLRK1; NKG2-D; NKG2D
UniProt ID: (Human) P26718
Entrez Gene ID: (Human) 22914